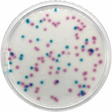

LET OP: de gemiddelde levertijd van dit artikel is 3 a 4 weken. Informeer naar de mogelijkheden tot voorraad houden.
E. coli–Coliforms Supplement (BOE) is een selectief additief dat wordt gebruikt in combinatie met geschikte basismedia voor de detectie en telling van coliformen en E. coli. Het supplement verbetert de selectiviteit en onderdrukt ongewenste flora, waardoor betrouwbare resultaten worden verkregen in wateronderzoek, voedingsmiddelenanalyse en microbiologische kwaliteitscontrole. Geschikt voor routinematige laboratoriumtoepassingen.
-
Merk
-
Merk artikelnummer
De chemicaliën in deze categorie zijn uitsluitend bedoeld voor professioneel laboratorium-, onderzoeks- of onderwijsgebruik door bevoegde organisaties en personen. Controleer vóór aankoop en toepassing altijd het meest recente veiligheidsinformatieblad (SDS), de lokale wet- en regelgeving (o.a. REACH, CLP, ADR) en de interne veiligheidsvoorschriften. Onjuist gebruik, opslag of verwijdering kan leiden tot ernstige gezondheids-, milieu- of materiële schade. Antonides aanvaardt geen aansprakelijkheid voor schade die voortvloeit uit onjuist of onveilig gebruik van de producten.